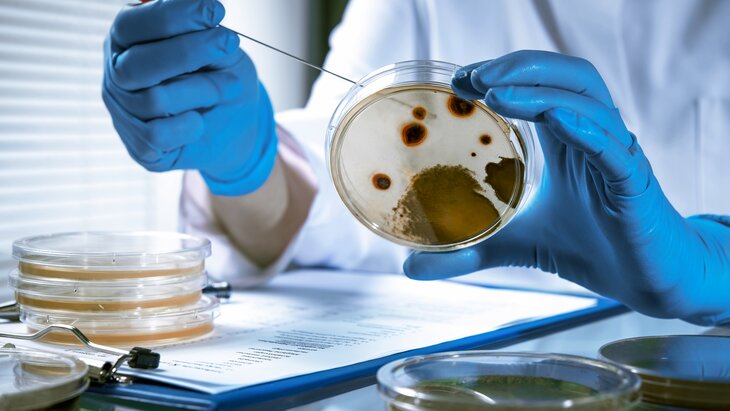

13 сентября 2022, 14:49
ПолитикаПретензии по военно-биологической деятельности на Украине остались без ответа – Рябков
Фото: depositphotos/alexraths
Большинство претензий России по военно-биологической деятельности на территории Украины остались без ответа со стороны Киева и Вашингтона. Об этом заявил замглавы МИД РФ Сергей Рябков.
"По итогам консультативного совещания констатируем, что подавляющее большинство выдвинутых Россией претензий осталось без должного ответа со стороны США и Украины", – приводит слова Рябкова ТАСС.
Он подчеркнул, что Вашингтон не хочет, чтобы информация об их военно-биологической деятельности, которая осуществляется в нарушение Конвенции о запрещении биологического и токсинного оружия (КБТО), стала известна мировому сообществу и общественности.
Рябков также рассказал, что деструктивная линия Вашингтона и Киева в ходе совещания государств КБТО свидетельствует об их настрое продолжать обеспечивать военно-биологические исследования Пентагона у границ РФ.
Замглавы МИД РФ добавил, что Москва разрабатывает вместе с рядом стран документы, позволяющие обмениваться информацией по биологической безопасности.
В середине июня в Минобороны РФ заявили, что Соединенные Штаты уже признали свою причастность к деятельности биолабораторий на постсоветском пространстве, в том числе на Украине. В частности, соответствующее официальное заявление было опубликовано на сайте Пентагона. В документе также шла речь о так называемой программе Нанна – Лугара.
Биологические лаборатории обнаружили на Украине 7 марта в ходе проводимой Россией специальной военной операции по защите ЛНР и ДНР. Военные нашли 30 лабораторий на территории страны. Как выяснилось позже, их деятельность финансировали Соединенные Штаты.
Ситуация обострилась после того, как в ночь на 24 февраля Владимир Путин заявил, что принял решение о проведении специальной операции в Донбассе. О помощи в отражении агрессии со стороны ВСУ попросили президента РФ главы Донецкой и Луганской народных республик Денис Пушилин и Леонид Пасечник.
В МО РФ заявили, что США могли быть причастны к появлению COVID-19








Собянин: более 80 спецкабинетов химии появится в обновленных школах Москвы






















